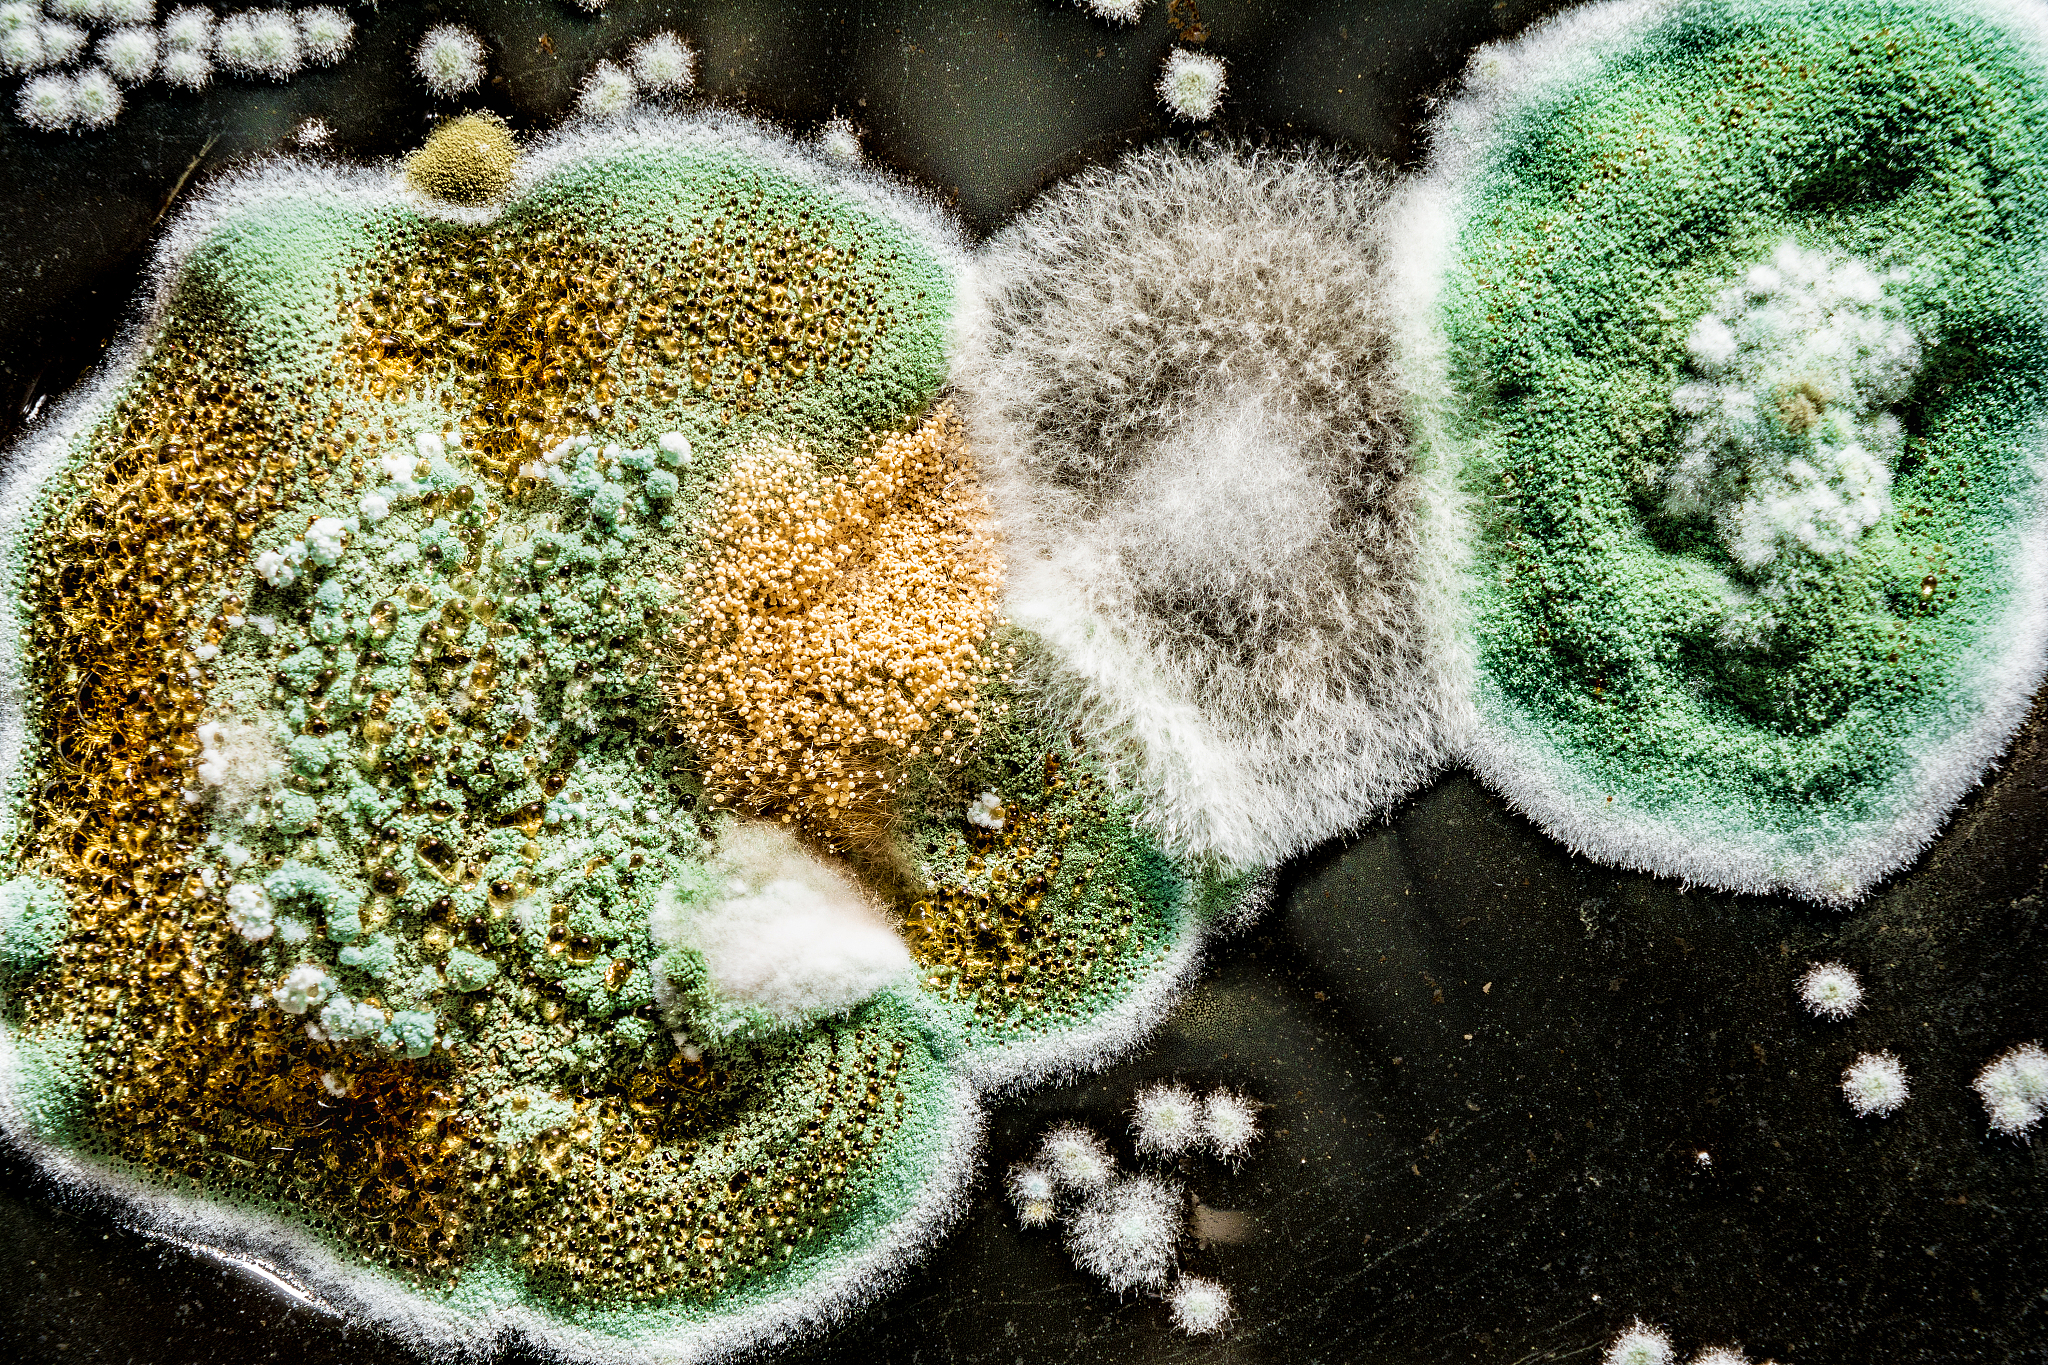
土壤细菌会变成马链球菌吗？

土壤细菌会变成马链球菌吗?
马链球菌是一种常见的细菌,它可以在土壤中生长和繁殖,但是通常情况下,土壤里的细菌不会自行发酵成马链球菌。马链球菌通常是通过接触感染或食物污染等途径传播的。

原文地址: https://www.cveoy.top/t/topic/oQrx 著作权归作者所有。请勿转载和采集!
安全问答是一个知识全球问答,包含丰富的问答知识
马链球菌是一种常见的细菌,它可以在土壤中生长和繁殖,但是通常情况下,土壤里的细菌不会自行发酵成马链球菌。马链球菌通常是通过接触感染或食物污染等途径传播的。
原文地址: https://www.cveoy.top/t/topic/oQrx 著作权归作者所有。请勿转载和采集!